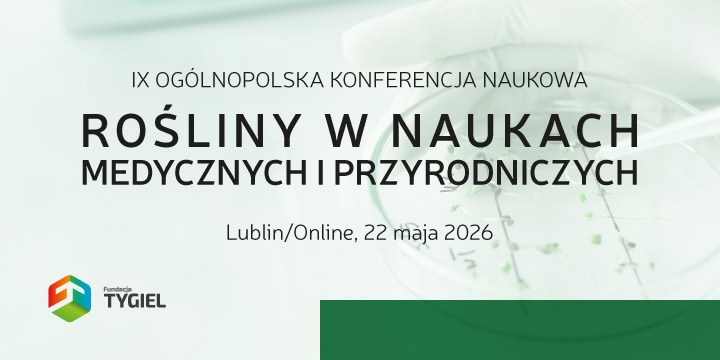

• prestiżowe wydarzenie naukowe dla naukowców, doktorantów, studentów, pracowników oraz pasjonatów
• aktualna i ważna tematyka
• prace badawcze i przeglądowe
• wystąpienia ustne oraz prezentacje posterów
• publikacja artykułów
• profesjonalna obsługa i organizacja wydarzenia
• uczestnictwo w formie stacjonarnej lub zdalnej
Serdecznie zapraszamy do udziału w IX Ogólnopolskiej Konferencji Naukowej „Rośliny w naukach medycznych i przyrodniczych”. Podczas Konferencji przedstawione zostaną prace z zakresu nauk medycznych, farmaceutycznych oraz przyrodniczych. Celem Konferencji jest wymiana doświadczeń dotyczących praktycznego zastosowania roślin w profilaktyce zdrowotnej, terapii chorób, farmacji, kosmetologii oraz biotechnologii.
Lecznicze właściwości roślin znane są ludzkości już od początków medycyny w Babilonii 2000 lat p.n.e. Do dnia dzisiejszego poznaliśmy ponad 2500 gatunków roślin leczniczych. Stanowią one nie tylko istotny element medycyny i farmacji, ale stały się również powszechnym źródłem substancji biologicznie czynnych, wykorzystywanych w naukach przyrodniczych, m.in. w uprawie roślin, czy też jako naturalne komponenty produktów codziennego użytku. Według Światowej Organizacji Zdrowia rośliny są składnikiem 25% leków stosowanych na świecie, a w niektórych populacjach leki pochodzenia roślinnego są podstawowym elementem opieki zdrowotnej – stanowią do 80% wszystkich form terapii. Nieoceniony jest również udział związków roślinnych w profilaktyce zdrowotnej oraz kosmetologii i zabiegach estetycznych.
Wychodząc naprzeciw wyzwaniom współczesnych badań naukowych, pragniemy zaprosić Państwa do prezentacji doniesień i badań dotyczących zastosowania roślin w naukach medycznych i pokrewnych, a także przyrodniczych. Do udziału w konferencji zapraszamy specjalistów, naukowców, w tym także studentów i doktorantów zainteresowanych interdyscyplinarną wymianą doświadczeń z zakresu tematyki Konferencji.

Tytuł wystąpienia:
Bioaktywne związki roślinne w prewencji chorób neurodegeneracyjnych

Tytuł wystąpienia:
Zawartość związków biologicznie czynnych w owocach i warzywach ekologicznych

Tytuł wystąpienia:
Zielone oblicza nanotechnologii: rola roślin w syntezie nanomateriałów i zastosowanie nanotechnologii w uprawie roślin
*opłatę rejestracyjną oraz za rozdział w monografii należy uiścić w ciągu 7 dni od daty otrzymania potwierdzenia rejestracji uczestnictwa w Konferencji, jednak nie później niż 14 dni przed wydarzeniem. Brak wpłaty w podanym terminie oznacza rezygnację z udziału w wydarzeniu i usunięcie zgłoszenia z rejestracji.
**opłata dotyczy jednego wystąpienia, za każde kolejne wystąpienie obowiązuje dodatkowa opłata w wysokości 50% wniesionej kwoty opłaty konferencyjnej.
***opłata dotyczy jednego rozdziału w monografii, za każdy kolejny rozdział obowiązuje dodatkowa opłata w wysokości 399 zł.
^tylko w przypadku udziału w formie stacjonarnej
Dane do wpłat
Fundacja na rzecz promocji nauki i rozwoju TYGIEL
ul. Głowackiego 35/348, 20-060 Lublin
NIP 946-26-49-975
Numer rachunku: 70 1140 2004 0000 3102 7533 8307
Nazwa Banku: mBank (BRE Wydz. Bankowości Elektronicznej)
Tytuły przelewów w przypadku:
– uczestnictwa bierne/czynne – Rośliny IX udział Imię i nazwisko
– uczestnictwa bierne/czynne oraz rozdziału – Rośliny IX udział+rozdział Imię i nazwisko
Prosimy o przesłanie potwierdzenia przelewu na adres: .....@konferencja-rosliny.pl w ciągu 7 dni od daty dokonania przelewu.
Faktury
Osoby zainteresowane otrzymaniem faktury proszone są o przesłanie danych (tj. nazwa, adres oraz NIP) na adres .....@konferencja-rosliny.pl w ciągu 7 dni od daty dokonania płatności.
Faktury są wystawiane wyłącznie na mailową prośbę uczestnika. Tylko tak dokonane zgłoszenie powoduje przesłanie faktury drogą elektroniczną oraz uprawnia do odbioru wersji papierowej podczas rejestracji w dniu Konferencji. W przypadku pytań bądź wątpliwości prosimy o kontakt mailowy.


Wystąpienia ustne
Czynni uczestnicy Konferencji mają możliwość prezentacji swoich prac w formie wystąpień ustnych i/lub posterów naukowych. Tematyka wystąpień musi być związana z zagadnieniami poruszanymi podczas Konferencji. Wystąpienia mogą być przygotowane zarówno na podstawie badań własnych Autora, jak też stanowić przedstawienie zagadnienia pod kątem teoretycznym.
Uczestnik może dołączyć do wystąpienia prezentację multimedialną. Prezentacja musi zostać przygotowana w języku polskim w programie PowerPoint, a następnie przesłana na adres mailowy .....@konferencja-rosliny.pl w dokumencie o rozszerzeniu PDF do dnia 20 maja 2026 roku. Dzięki temu zostanie sprawdzona poprawność odczytu prezentacji. Dokument z prezentacją należy nazwać zgodnie ze wzorem „Nazwisko i Imię, Rośliny IX, pierwsze 3 słowa z tytułu wystąpienia”.
Czas wystąpienia: 15 min.
Prezentacje mogą mieć maksymalnie 3 autorów. Istnieje możliwość odstępstwa od ograniczenia maksymalnej liczby autorów, jednak po uprzednim zgłoszeniu faktu drogą mailową na adres .....@konferencja-rosliny.pl i uzyskaniu jednoznacznej aprobaty ze strony Komitetu Organizacyjnego.
Jak przygotować poster naukowy?
W przypadku prezentacji posteru prosimy o przygotowanie go jedynie w formie elektronicznej w orientacji poziomej lub w postaci krótkiej prezentacji (2-4 slajdy).
Pracę należy przesłać na adres mailowy .....@konferencja-rosliny.pl w dokumencie o rozszerzeniu PDF do dnia 20 maja 2026 roku. Dzięki temu zostanie sprawdzona poprawność odczytu posteru. Dokument z posterem należy nazwać zgodnie ze wzorem „Nazwisko i Imię, Rośliny IX, pierwsze 3 słowa z tytułu wystąpienia”.
Czas prezentacji posteru: 5 min.
Postery naukowe mogą mieć maksymalnie 3 autorów. Istnieje możliwość odstępstwa od ograniczenia maksymalnej liczby autorów, jednak po uprzednim zgłoszeniu faktu drogą mailową na adres .....@konferencja-rosliny.pl i uzyskaniu jednoznacznej aprobaty ze strony Komitetu Organizacyjnego.
Dodatkowe informacje
Osoby uczestniczące zdalnie, będą miały możliwości wysłuchania na żywo wszystkich wystąpień podczas Konferencji. Wygłoszenia swojej pracy będą mogli dokonać za pośrednictwem platformy internetowej. Uczestnicy otrzymają drogą mailową link do wydarzenia najpóźniej w dniu Konferencji.
Przydatne informacje dotyczące zgłoszenia abstraktów:
• abstrakty wystąpień ustnych oraz posterów naukowych należy zgłaszać za pośrednictwem formularza elektronicznego do dnia 14 maja 2026 r.,
• tytuły prac oraz ich abstrakty powinny być przygotowane w języku polskim oraz angielskim,
• długość jednego abstraktu to 1000 do 1500 znaków ze spacjami,
• abstrakt powinien zostać napisany w formie bezosobowej i aspekcie dokonanym,
• treść abstraktu to odpowiedź na podstawowe pytania: Jaki jest cel pracy? Co w niej przedstawiono?
– należy opisać zakres tematyczny opracowania,
– wymienić główne metody użyte w opracowaniu,
– wyjaśnić, co wynika z przeprowadzonej analizy, dyskusji oraz uzyskanych wyników,
– podać główne wnioski oraz ewentualne założenia badawcze do dalszych prac lub zastosowania praktyczne,
• wystąpienia ustne oraz postery naukowe mogą mieć maksymalnie 3 autorów (istnieje możliwość odstępstwa, jednak po uprzednim zgłoszeniu tego na adres .....@konferencja-rosliny.pl i uzyskaniu jednoznacznej zgody Komitetu Organizacyjnego).


Informacje ogólne
W ramach uczestnictwa w wydarzeniu proponujemy Państwu możliwość opublikowania swoich prac naukowych w formie rozdziału w monografii naukowej (po publikacji prace będą dostępne w formie open access). Wydane monografie, spełniają kryteria uwzględniane przy ocenie ewaluacyjnej dorobku naukowego, a także są satysfakcjonującym sposobem przedstawienia swojej wiedzy.
Wydawca publikacji:
Monografia zostanie wydana nakładem Wydawnictwa Naukowego TYGIEL, które zostało ujęte w wykazie wydawnictw publikujących recenzowane monografie naukowe, zgodnie z komunikatem Ministra Edukacji i Nauki z dnia 22 lipca 2021 r., który dostępny jest >>tutaj<<.
Zgłoszenie rozdziału:
• w formularzu rejestracji uczestnictwa należy zaznaczyć deklarację chęci opublikowania rozdziału w monografii naukowej;
• przekazanie podczas wydarzenia lub dostarczenie do biura Fundacji TYGIEL (ul B. Głowackiego 35/348, 20-060 Lublin) oświadczenia autorów z oryginalnymi podpisami wszystkich współautorów pracy oraz takim samym tytułem jaki został podany w przesłanej wersji elektronicznej. Na kopercie proszę dopisać nazwę wydarzenia (druk Oświadczenia Autorów do pobrania >>tutaj<<);
• przesłanie mailowo na adres .....@konferencja-rosliny.pl rozdziału zgodnego z ustalonym wzorem formatowania: przypisy końcowe (UWAGA, prosimy o korzystanie z aktualnej wersji do pobrania >>tutaj<<);
• uwzględnienie ewentualnych wskazówek edytorskich i technicznych wskazanych przez Organizatora.
Autorzy są zobligowani do przesłania pracy zgodnie z datą podaną na stronie wydarzenia w zakładce Terminy. W przypadku wystąpienia opóźnień w przygotowaniu rozdziału, skutkujących nieprzesłaniem pracy w terminie, prosimy o wcześniejszy kontakt mailowy w celu podjęcia indywidualnych ustaleń. Niedotrzymanie terminu może spowodować opóźnienie w publikacji.
Udział w Konferencji będzie możliwy zarówno w formie stacjonarnej, jak i zdalnej. Dołożymy wszelkich starań, aby zapewnić wszystkim uczestnikom, członkom Komitetu Naukowego i Gościom Honorowym możliwość owocnej dyskusji, a także wzajemnej integracji.
Miejsce stacjonarnej części wydarzenia zostanie podane bliżej terminu.


Platforma streamingowa
Konferencja odbędzie się za pośrednictwem Platformy ClickMeeting. Pozwoli ona na udział w wydarzeniu poprzez urządzenia mobilne, takie jak: laptop, smartfon, tablet, komputer stacjonarny (uczestnikom czynnym rekomendujemy, aby podczas przedstawiania prezentacji korzystali z komputera stacjonarnego, laptopa lub aplikacji mobilnej ClickMeeting).
Funkcjonalność platformy:
• możliwość wystąpienia dwóch Prelegentów jednocześnie,
• podjęcie dyskusji po wystąpieniu w formie czatu,
• udostępnienie możliwości zabrania głosu wybranym Uczestnikom Wydarzenia,
• obecność i ciągłe wsparcie Organizatorów Konferencji,
• wyświetlenie prezentacji przez Prelegenta oraz możliwość rysowania po slajdach,
• udostępnianie ekranu przez Prelegenta w trakcie wystąpienia.
Aby bez przeszkód móc uczestniczyć w wydarzeniu użytkując platformę ClickMeeting wystarczy dostęp do Internetu i aktualna przeglądarka internetowa (Chrome, Opera, Firefox, Edge). Zaleca się używać komputer z 4-wątkowym procesorem, min. 8 GB pamięci RAM i aktualnym systemem operacyjnym Windows 8.1, Windows 10 lub Windows 11. W praktyce jednak wystarczy dowolny sprzęt, który płynnie wykonuje zadania biurowe. Platforma streamingowa działa także na systemach operacyjnych Apple oraz dystrybucjach Linux, w tym – systemie Android i ChromeOS.
Do czynnego udziału w Konferencji niezbędny jest mikrofon, zalecamy także zastosowanie kamery internetowej.
Wystąpienie online nie jest łatwe i często bywa stresujące nawet dla profesjonalistów. Dlatego przygotowaliśmy dla Państwa kilka wskazówek, których wdrożenie pozwoli na jeszcze bardziej owocny udział poprzez zwiększenie komfortu osoby prezentującej, jak i pozostałych uczestników.
Zachęcamy do zapoznania się z >>tym<< materiałem, który jest dostępny także w zakładce Do pobrania.
W związku z licznymi prośbami informujemy, że udział w Konferencji będzie możliwy zarówno w formie stacjonarnej, jak i zdalnej. Szczegóły można znaleźć w poszczególnych zakładkach.
Każda osoba zainteresowana udziałem stacjonarnym/zdalnym w Konferencji zobligowana jest do rejestracji uczestnictwa poprzez dostępny poniżej formularz rejestracji uczestnictwa.
Rejestracji trwa do 13 maja 2026 roku.
Rejestracja uczestnictwa w Konferencji -> kliknij tutaj
Uczestnicy, którzy planują przygotować wystąpienie ustne/postery naukowe są zobligowani do zarejestrowania jego tytułu i abstraktu poprzez formularz.
Rejestracja tytułów i abstraktów wystąpień -> kliknij tutaj
Rejestracja uczestnictwa -> kliknij tutaj
Rejestracja tytułów wystąpień i abstraktów -> kliknij tutaj

Fundacja na rzecz promocji nauki i rozwoju TYGIEL
e-mail: .....@konferencja-rosliny.pl
tel.: 733 933 ...
ul. Głowackiego 35/348, 20-060 Lublin
NIP: 946-26-49-975
REGON: 061730828
KRS: 0000524667
Konto bankowe PL – mBank:
70 1140 2004 0000 3102 7533 8307
EUR account: PL02 1140 2004 0000 3312 1237 8057
USD account: PL08 1140 2004 0000 3712 1253 7124







